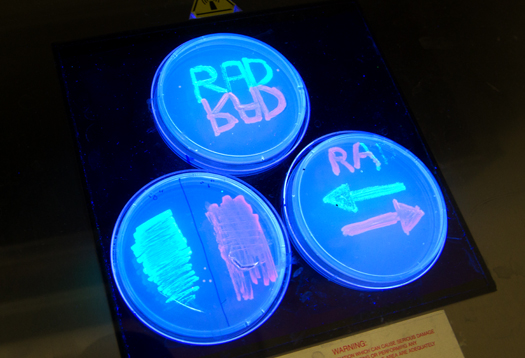

Νέα έρευνα αποκαλύπτει το ρόλο της γενετικής στην τεμπελιά

Ευρωπαϊκή σύσταση στη Ρουμανία για ελέγχους σε κρέατα

«Μίλησε» το DNA για τους συλληφθέντες της Κοζάνης

«Ξεκλειδώθηκε» το DNA του περιστεριού

«Ξεκλειδώθηκε» το DNA του ρεβιθιού

Νέο όπλο κατά των κακοποιών στις ΗΠΑ

Μετέτρεψαν το DNA σε μέσο αποθήκευσης

Τα σονέτα του Shakespeare τώρα και σε… DNA!

Βρέθηκε DNA με τετραπλή έλικα

Τεστ DNA «προβλέπει» υποτροπές του καρκίνου του μαστού

Το περιβάλλον της μήτρας «ευθύνεται» για την ομοφυλοφιλία

«Ξεκλείδωσαν» τα γενετικά μυστικά του καρπουζιού

Η μεγάλη επιστροφή της Τσιτσιολίνα

Έμβρυα από… τρεις γονείς

Στην Κύπρο ο νομπελίστας Τζέϊμς Γουότσον

Το DNA του αγοριού μπορεί να προστατεύσει τη μητέρα από το Αλτσχάιμερ

Εξιχνιάστηκε δολοφονία του 1974 στον Καναδά

Ανακαλύφθηκαν γονίδια που συνδέονται με την κατασκευή του προσώπου

Τα «σκουπίδια» του DNA κρύβουν πολύτιμες θεραπείες

H ταυτοποίηση του DNA οδήγησε στον βομβιστή

Ο ρόλος της γενετικής πληροφορίας στη διατροφή